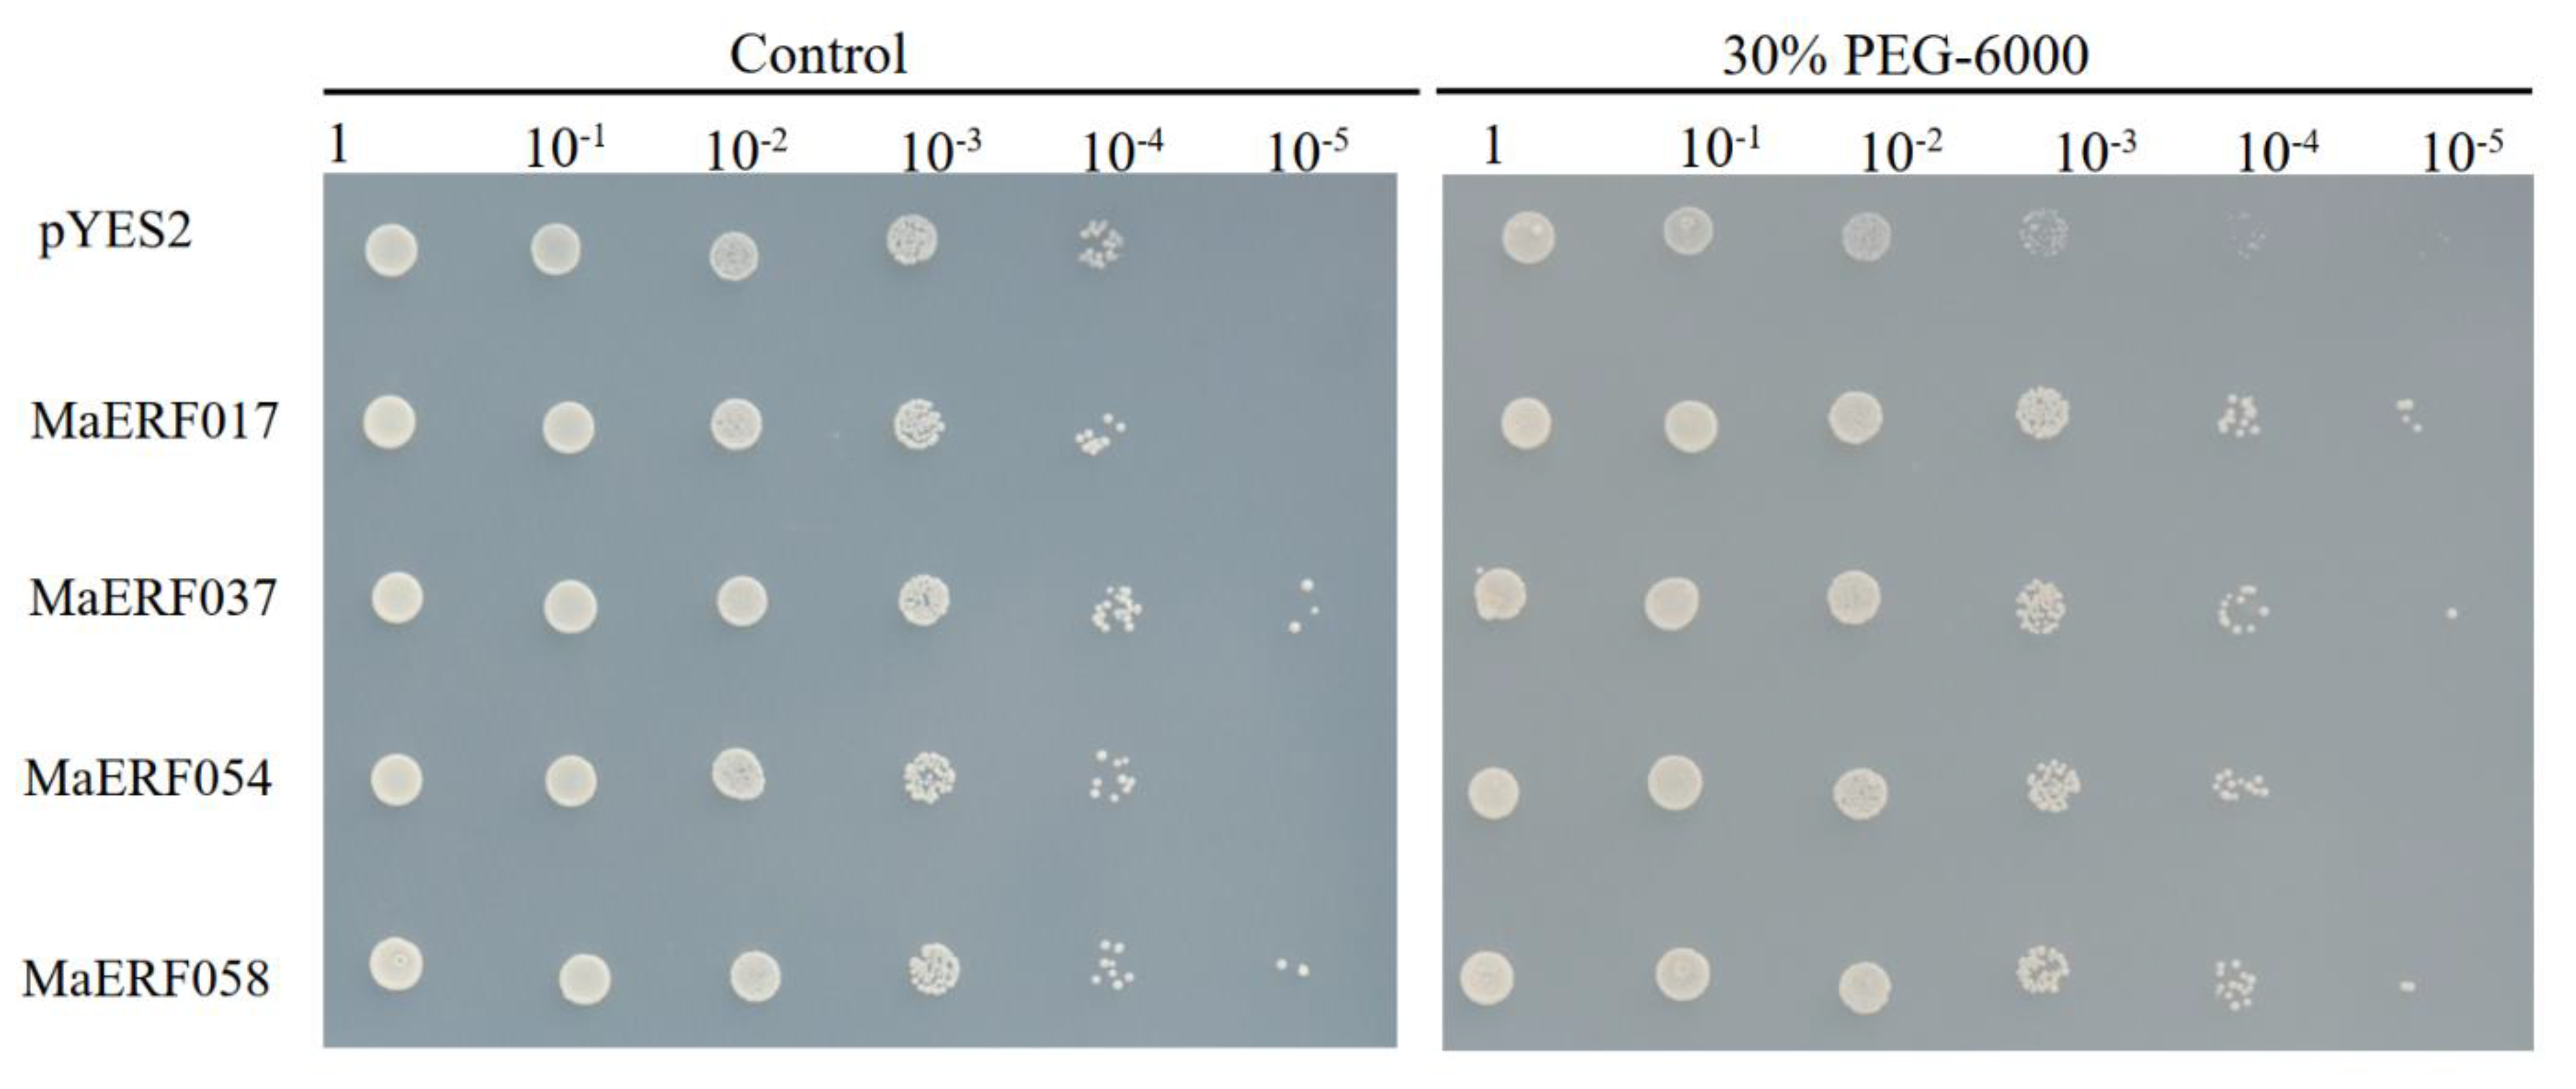
Ijms 23 12023 g009 Ijms 23 12023 g009

Genome-Wide Identification of ERF Transcription Factor Family and Functional Analysis of the Drought Stress-Responsive Genes in Melilotus albus
Abstract
1. Introduction
2. Results
2.1. Gene Identification and Chromosomal Localization of MaERFs
2.2. Phylogenetic Evolution and Physicochemical Properties Analysis of MaERFs
2.3. Multiple Sequence Alignment and Motif Distribution and Gene Structure Analysis of MaERFs
2.4. Duplication Events and Ka/Ks Analysis of the MaERFs
2.5. Expression Pattern Analysis in Response to Drought Stress of MaERFs
2.6. qRT-PCR Validation of MaERF Genes Expression
2.7. Analysis of cis-Acting Elements and Protein-Protein Interaction Networks of MaERFs
2.8. Transgenic Yeast to Analysis Drought Stresses
3. Discussion
4. Materials and Methods
4.1. Identification of the ERF Gene Family in M. albus
4.2. Chromosomal Location and Phylogenetic Analysis of MaERF Genes
4.3. AP2/ERF Domain Analysis of MaERF Genes
4.4. Conserved Motif and Gene Structure Analysis of MaERF Genes
4.5. Gene Duplication Events and Ka/Ks Analysis of MaERF Genes
4.6. Expression Analysis of MaERF Genes under Drought Stresses
4.7. Analysis of Cis-Acting Elements and Protein-Protein Interaction Networks of MaERF Genes
4.8. Plant Cultivation and Drought Treatments
4.9. Plant RNA Extraction and Quantitative Real-Time PCR Analysis
4.10. Yeast Heterologous Expression and Functional Validation of MaERF Genes
5. Conclusions
Supplementary Materials
Author Contributions
Funding
Institutional Review Board Statement
Informed Consent Statement
Conflicts of Interest
References
- Boyer, J.S. Plant productivity and environment. Science 1982, 218, 443–448. [Google Scholar] [CrossRef] [PubMed]
- Farooq, M.; Wahid, A.; Kobayashi, N.; Fujita, D.; Basra, S. Plant drought stress: Effects, mechanisms and management. In Sustainable Agriculture; Springer: Berlin, Germany, 2009; pp. 153–188. [Google Scholar]
- Nakashima, K.; Ito, Y.; Yamaguchi-Shinozaki, K. Transcriptional regulatory networks in response to abiotic stresses in Arabidopsis and grasses. Plant Physiol. 2009, 149, 88–95. [Google Scholar] [CrossRef]
- Almeida, D.M.; Gregorio, G.B.; Oliveira, M.M.; Saibo, N.J. Five novel transcription factors as potential regulators of OsNHX1 gene expression in a salt tolerant rice genotype. Plant Mol. Biol. 2017, 93, 61–77. [Google Scholar] [CrossRef]
- Mizoi, J.; Shinozaki, K.; Yamaguchi-Shinozaki, K. AP2/ERF family transcription factors in plant abiotic stress responses. Biochim. Et Biophys. Acta (BBA)-Gene Regul. Mech. 2012, 1819, 86–96. [Google Scholar] [CrossRef]
- Riechmann, J.L.; Heard, J.; Martin, G.; Reuber, L.; Jiang, C.-Z.; Keddie, J.; Adam, L.; Pineda, O.; Ratcliffe, O.; Samaha, R. Arabidopsis transcription factors: Genome-wide comparative analysis among eukaryotes. Science 2000, 290, 2105–2110. [Google Scholar] [CrossRef] [PubMed]
- Xu, Z.S.; Chen, M.; Li, L.C.; Ma, Y.Z. Functions and application of the AP2/ERF transcription factor family in crop improvement F. J. Integr. Plant Biol. 2011, 53, 570–585. [Google Scholar] [CrossRef] [PubMed]
- Trupiano, D.; Yordanov, Y.; Regan, S.; Meilan, R.; Tschaplinski, T.; Scippa, G.S.; Busov, V. Identification, characterization of an AP2/ERF transcription factor that promotes adventitious, lateral root formation in Populus. Planta 2013, 238, 271–282. [Google Scholar] [CrossRef] [PubMed]
- Jin, X.; Yin, X.; Ndayambaza, B.; Zhang, Z.; Min, X.; Lin, X.; Wang, Y.; Liu, W. Genome-wide identification and expression profiling of the ERF gene family in Medicago sativa L. under various abiotic stresses. DNA Cell Biol. 2019, 38, 1056–1068. [Google Scholar] [CrossRef] [PubMed]
- Li, X.; Zhang, D.; Li, H.; Wang, Y.; Zhang, Y.; Wood, A.J. EsDREB2B, a novel truncated DREB2-type transcription factor in the desert legume Eremosparton songoricum, enhances tolerance to multiple abiotic stresses in yeast and transgenic tobacco. BMC Plant Biol. 2014, 14, 44. [Google Scholar] [CrossRef]
- Ohme-Takagi, M.; Shinshi, H. Ethylene-inducible DNA binding proteins that interact with an ethylene-responsive element. Plant Cell 1995, 7, 173–182. [Google Scholar]
- Hao, D.; Ohme-Takagi, M.; Sarai, A. Unique mode of GCC box recognition by the DNA-binding domain of ethylene-responsive element-binding factor (ERF domain) in plant. J. Biol. Chem. 1998, 273, 26857–26861. [Google Scholar] [CrossRef]
- Hao, D.; Yamasaki, K.; Sarai, A.; Ohme-Takagi, M. Determinants in the sequence specific binding of two plant transcription factors, CBF1 and NtERF2, to the DRE and GCC motifs. Biochemistry 2002, 41, 4202–4208. [Google Scholar] [CrossRef] [PubMed]
- Lin, Z.; Hong, Y.; Yin, M.; Li, C.; Zhang, K.; Grierson, D. A tomato HD-Zip homeobox protein, LeHB-1, plays an important role in floral organogenesis and ripening. Plant J. 2008, 55, 301–310. [Google Scholar] [CrossRef] [PubMed]
- Lee, S.-Y.; Hwang, E.Y.; Seok, H.-Y.; Tarte, V.N.; Jeong, M.S.; Jang, S.B.; Moon, Y.-H. Arabidopsis AtERF71/HRE2 functions as transcriptional activator via cis-acting GCC box or DRE/CRT element and is involved in root development through regulation of root cell expansion. Plant Cell Rep. 2015, 34, 223–231. [Google Scholar] [CrossRef] [PubMed]
- Klay, I.; Gouia, S.; Liu, M.; Mila, I.; Khoudi, H.; Bernadac, A.; Bouzayen, M.; Pirrello, J. Ethylene Response Factors (ERF) are differentially regulated by different abiotic stress types in tomato plants. Plant Sci. 2018, 274, 137–145. [Google Scholar] [CrossRef]
- Figueroa-Yañez, L.; Pereira-Santana, A.; Arroyo-Herrera, A.; Rodriguez-Corona, U.; Sanchez-Teyer, F.; Espadas-Alcocer, J.; Espadas-Gil, F.; Barredo-Pool, F.; Castaño, E.; Rodriguez-Zapata, L.C. RAP2. 4a is transported through the phloem to regulate cold and heat tolerance in papaya tree (Carica papaya cv. Maradol): Implications for protection against abiotic stress. PLoS ONE 2016, 11, e0165030. [Google Scholar] [CrossRef]
- Cheng, M.-C.; Liao, P.-M.; Kuo, W.-W.; Lin, T.-P. The Arabidopsis Ethylene Response Factor1 regulates abiotic stress-responsive gene expression by binding to different cis-acting elements in response to different stress signals. Plant Physiol. 2013, 162, 1566–1582. [Google Scholar] [CrossRef] [PubMed]
- Jung, H.; Chung, P.J.; Park, S.H.; Redillas, M.C.F.R.; Kim, Y.S.; Suh, J.W.; Kim, J.K. Overexpression of Os ERF 48 causes regulation of Os CML 16, a calmodulin-like protein gene that enhances root growth and drought tolerance. Plant Biotechnol. J. 2017, 15, 1295–1308. [Google Scholar] [CrossRef] [PubMed]
- Sakuma, Y.; Maruyama, K.; Osakabe, Y.; Qin, F.; Seki, M.; Shinozaki, K.; Yamaguchi-Shinozaki, K. Functional analysis of an Arabidopsis transcription factor, DREB2A, involved in drought-responsive gene expression. Plant Cell 2006, 18, 1292–1309. [Google Scholar] [CrossRef] [PubMed]
- Chen, J.-R.; Lü, J.-J.; Wang, T.-X.; Chen, S.-Y.; Wang, H.-F. Activation of a DRE-binding transcription factor from Medicago truncatula by deleting a Ser/Thr-rich region. Vitr. Cell. Dev. Biol. -Plant 2009, 45, 1–11. [Google Scholar] [CrossRef]
- Li, W.-Y.; Wang, C.; Shi, H.-H.; Wang, B.; Wang, J.-X.; Liu, Y.-S.; Ma, J.-Y.; Tian, S.-Y.; Zhang, Y.-W. Genome-wide analysis of ethylene-response factor family in adzuki bean and functional determination of VaERF3 under saline-alkaline stress. Plant Physiol. Biochem. 2020, 147, 215–222. [Google Scholar] [CrossRef] [PubMed]
- Luo, K.; Jahufer, M.; Wu, F.; Di, H.; Zhang, D.; Meng, X.; Zhang, J.; Wang, Y. Genotypic variation in a breeding population of yellow sweet clover (Melilotus officinalis). Front. Plant Sci. 2016, 7, 972. [Google Scholar] [CrossRef] [PubMed]
- Wu, F.; Duan, Z.; Xu, P.; Yan, Q.; Meng, M.; Cao, M.; Jones, C.S.; Zong, X.; Zhou, P.; Wang, Y. Genome and systems biology of Melilotus albus provides insights into coumarins biosynthesis. Plant Biotechnol. J. 2022, 20, 592. [Google Scholar] [CrossRef]
- Xie, L.-N.; Chen, M.; Min, D.-H.; Feng, L.; Xu, Z.-S.; Zhou, Y.-B.; Xu, D.-B.; Li, L.-C.; Ma, Y.-Z.; Zhang, X.-H. The NAC-like transcription factor SiNAC110 in foxtail millet (Setaria italica L.) confers tolerance to drought and high salt stress through an ABA independent signaling pathway. J. Integr. Agric. 2017, 16, 559–571. [Google Scholar] [CrossRef]
- Li, M.-Y.; Xu, Z.-S.; Huang, Y.; Tian, C.; Wang, F.; Xiong, A.-S. Genome-wide analysis of AP2/ERF transcription factors in carrot (Daucus carota L.) reveals evolution and expression profiles under abiotic stress. Mol. Genet. Genom. 2015, 290, 2049–2061. [Google Scholar] [CrossRef] [PubMed]
- Shu, Y.; Liu, Y.; Zhang, J.; Song, L.; Guo, C. Genome-wide analysis of the AP2/ERF superfamily genes and their responses to abiotic stress in Medicago truncatula. Front. Plant Sci. 2016, 6, 1247. [Google Scholar] [CrossRef]
- Yu, Y.; Duan, X.; Ding, X.; Chen, C.; Zhu, D.; Yin, K.; Cao, L.; Song, X.; Zhu, P.; Li, Q. A novel AP2/ERF family transcription factor from Glycine soja, GsERF71, is a DNA binding protein that positively regulates alkaline stress tolerance in Arabidopsis. Plant Mol. Biol. 2017, 94, 509–530. [Google Scholar] [CrossRef]
- Nakano, T.; Suzuki, K.; Fujimura, T.; Shinshi, H. Genome-wide analysis of the ERF gene family in Arabidopsis and rice. Plant Physiol. 2006, 140, 411–432. [Google Scholar] [CrossRef] [PubMed]
- Faraji, S.; Filiz, E.; Kazemitabar, S.K.; Vannozzi, A.; Palumbo, F.; Barcaccia, G.; Heidari, P. The AP2/ERF gene family in Triticum durum: Genome-wide identification and expression analysis under drought and salinity stresses. Genes 2020, 11, 1464. [Google Scholar] [CrossRef]
- Okamuro, J.K.; Caster, B.; Villarroel, R.; Van Montagu, M.; Jofuku, K.D. The AP2 domain of APETALA2 defines a large new family of DNA binding proteins in Arabidopsis. Proc. Natl. Acad. Sci. USA 1997, 94, 7076–7081. [Google Scholar] [CrossRef]
- Zhang, G.; Chen, M.; Chen, X.; Xu, Z.; Guan, S.; Li, L.-C.; Li, A.; Guo, J.; Mao, L.; Ma, Y. Phylogeny, gene structures, and expression patterns of the ERF gene family in soybean (Glycine max L.). J. Exp. Bot. 2008, 59, 4095–4107. [Google Scholar] [CrossRef]
- Tang, Y.; Qin, S.; Guo, Y.; Chen, Y.; Wu, P.; Chen, Y.; Li, M.; Jiang, H.; Wu, G. Genome-wide analysis of the AP2/ERF gene family in physic nut and overexpression of the JcERF011 gene in rice increased its sensitivity to salinity stress. PLoS ONE 2016, 11, e0150879. [Google Scholar] [CrossRef]
- Zhang, Z.; Li, X. Genome-wide identification of AP2/ERF superfamily genes and their expression during fruit ripening of Chinese jujube. Sci. Rep. 2018, 8, 15612. [Google Scholar] [CrossRef]
- Li, D.; Liu, X.; Shu, L.; Zhang, H.; Zhang, S.; Song, Y.; Zhang, Z. Global analysis of the AP2/ERF gene family in rose (Rosa chinensis) genome unveils the role of RcERF099 in Botrytis resistance. BMC Plant Biol. 2020, 20, 533. [Google Scholar] [CrossRef]
- Zafar, M.M.; Rehman, A.; Razzaq, A.; Parvaiz, A.; Mustafa, G.; Sharif, F.; Mo, H.; Youlu, Y.; Shakeel, A.; Ren, M. Genome-wide characterization and expression analysis of Erf gene family in cotton. BMC Plant Biol. 2022, 22, 134. [Google Scholar] [CrossRef]
- Wang, Q.; Wei, N.; Jin, X.; Min, X.; Ma, Y.; Liu, W. Molecular characterization of the COPT/Ctr-type copper transporter family under heavy metal stress in alfalfa. Int. J. Biol. Macromol. 2021, 181, 644–652. [Google Scholar] [CrossRef]
- Nakashima, K.; Yamaguchi-Shinozaki, K.; Shinozaki, K. The transcriptional regulatory network in the drought response and its crosstalk in abiotic stress responses including drought, cold, and heat. Front. Plant Sci. 2014, 5, 170. [Google Scholar] [CrossRef]
- Santner, A.; Estelle, M. Recent advances and emerging trends in plant hormone signalling. Nature 2009, 459, 1071–1078. [Google Scholar] [CrossRef]
- Zhou, Q.; Jia, C.; Ma, W.; Cui, Y.; Jin, X.; Luo, D.; Min, X.; Liu, Z. MYB transcription factors in alfalfa (Medicago sativa): Genome-wide identification and expression analysis under abiotic stresses. PeerJ 2019, 7, e7714. [Google Scholar] [CrossRef] [PubMed]
- Trujillo, L.; Sotolongo, M.; Menendez, C.; Ochogavia, M.; Coll, Y.; Hernandez, I.; Borras-Hidalgo, O.; Thomma, B.; Vera, P.; Hernandez, L. SodERF3, a novel sugarcane ethylene responsive factor (ERF), enhances salt and drought tolerance when overexpressed in tobacco plants. Plant Cell Physiol. 2008, 49, 512–525. [Google Scholar] [CrossRef] [PubMed]
- Xie, Z.; Nolan, T.M.; Jiang, H.; Yin, Y. AP2/ERF transcription factor regulatory networks in hormone and abiotic stress responses in Arabidopsis. Front. Plant Sci. 2019, 10, 228. [Google Scholar] [CrossRef]
- Anderson, J.P.; Lichtenzveig, J.; Gleason, C.; Oliver, R.P.; Singh, K.B. The B-3 ethylene response factor MtERF1-1 mediates resistance to a subset of root pathogens in Medicago truncatula without adversely affecting symbiosis with rhizobia. Plant Physiol. 2010, 154, 861–873. [Google Scholar] [CrossRef]
- Seo, Y.J.; Park, J.-B.; Cho, Y.-J.; Jung, C.; Seo, H.S.; Park, S.-K.; Nahm, B.H.; Song, J.T. Overexpression of the ethylene-responsive factor gene BrERF4 from Brassica rapa increases tolerance to salt and drought in Arabidopsis plants. Mol. Cells 2010, 30, 271–277. [Google Scholar] [CrossRef]
- Min, X.; Jin, X.; Zhang, Z.; Wei, X.; Ndayambaza, B.; Wang, Y.; Liu, W. Genome-Wide Identification of NAC Transcription Factor Family and Functional Analysis of the Abiotic Stress-Responsive Genes in Medicago sativa L. J. Plant Growth Regul. 2020, 39, 324–337. [Google Scholar] [CrossRef]
- Zhang, Z.; Jin, X.; Liu, Z.; Zhang, J.; Liu, W. Genome-wide identification of FAD gene family and functional analysis of MsFAD3. 1 involved in the accumulation of α-linolenic acid in alfalfa. Crop Sci. 2021, 61, 566–579. [Google Scholar] [CrossRef]
- Gasteiger, E.; Gattiker, A.; Hoogland, C.; Ivanyi, I.; Appel, R.D.; Bairoch, A. ExPASy: The proteomics server for in-depth protein knowledge and analysis. Nucleic Acids Res. 2003, 31, 3784–3788. [Google Scholar] [CrossRef] [PubMed]
- Kumar, S.; Stecher, G.; Li, M.; Knyaz, C.; Tamura, K. MEGA X: Molecular evolutionary genetics analysis across computing platforms. Mol. Biol. Evol. 2018, 35, 1547. [Google Scholar] [CrossRef] [PubMed]
- Zhao, S.-P.; Xu, Z.-S.; Zheng, W.-J.; Zhao, W.; Wang, Y.-X.; Yu, T.-F.; Chen, M.; Zhou, Y.-B.; Min, D.-H.; Ma, Y.-Z. Genome-wide analysis of the RAV family in soybean and functional identification of GmRAV-03 involvement in salt and drought stresses and exogenous ABA treatment. Front. Plant Sci. 2017, 8, 905. [Google Scholar] [CrossRef] [PubMed]
- Edwards, D.J.; Grodevant, N.W.; Lee, P.J.; Peralta, J.B. DNA-MAN: Dynamic Natural Attributes for Synthetic Military Forces. In Proceedings of the 2007 IEEE Systems and Information Engineering Design Symposium, Charlottesville, VA, USA, 27 April 2007; pp. 1–5. [Google Scholar]
- Crooks, G.E.; Hon, G.; Chandonia, J.-M.; Brenner, S.E. WebLogo: A sequence logo generator. Genome Res. 2004, 14, 1188–1190. [Google Scholar] [CrossRef]
- Bailey, T.L.; Johnson, J.; Grant, C.E.; Noble, W.S. The MEME suite. Nucleic Acids Res. 2015, 43, W39–W49. [Google Scholar] [CrossRef]
- Hu, B.; Jin, J.; Guo, A.-Y.; Zhang, H.; Luo, J.; Gao, G. GSDS 2.0: An upgraded gene feature visualization server. Bioinformatics 2015, 31, 1296–1297. [Google Scholar] [CrossRef] [PubMed]
- Wang, Y.; Tang, H.; DeBarry, J.D.; Tan, X.; Li, J.; Wang, X.; Lee, T.-H.; Jin, H.; Marler, B.; Guo, H. MCScanX: A toolkit for detection and evolutionary analysis of gene synteny and collinearity. Nucleic Acids Res. 2012, 40, e49. [Google Scholar] [CrossRef] [PubMed]
- Chen, C.; Chen, H.; Zhang, Y.; Thomas, H.R.; Frank, M.H.; He, Y.; Xia, R. TBtools: An integrative toolkit developed for interactive analyses of big biological data. Mol. Plant 2020, 13, 1194–1202. [Google Scholar] [CrossRef] [PubMed]
- Duan, Z.; Yan, Q.; Wu, F.; Wang, Y.; Wang, S.; Zong, X.; Zhou, P.; Zhang, J. Genome-Wide Analysis of the UDP-Glycosyltransferase Family Reveals Its Roles in Coumarin Biosynthesis and Abiotic Stress in Melilotus albus. Int. J. Mol. Sci. 2021, 22, 10826. [Google Scholar] [CrossRef]
- Lescot, M.; Déhais, P.; Thijs, G.; Marchal, K.; Moreau, Y.; Van de Peer, Y.; Rouzé, P.; Rombauts, S. PlantCARE, a database of plant cis-acting regulatory elements and a portal to tools for in silico analysis of promoter sequences. Nucleic Acids Res. 2002, 30, 325–327. [Google Scholar] [CrossRef]
- Franceschini, A.; Szklarczyk, D.; Frankild, S.; Kuhn, M.; Simonovic, M.; Roth, A.; Lin, J.; Minguez, P.; Bork, P.; von Mering, C.; et al. STRING v9.1: Protein-protein interaction networks, with increased coverage and integration. Nucleic Acids Res. 2013, 41, D808–D815. [Google Scholar] [CrossRef] [PubMed]
- Ma, Y.; Wei, N.; Wang, Q.; Liu, Z.; Liu, W. Genome-wide identification and characterization of the heavy metal ATPase (HMA) gene family in Medicago truncatula under copper stress. Int. J. Biol. Macromol. 2021, 193, 893–902. [Google Scholar] [CrossRef] [PubMed]
- Luo, D.; Liu, J.; Wu, Y.; Zhang, X.; Zhou, Q.; Fang, L.; Liu, Z. Nuclear transport factor 2-LIKE improves drought tolerance by modulating leaf water loss in alfalfa (Medicago sativa L.). Plant J. 2022. [Google Scholar] [CrossRef]
- Dong, R.; Dong, D.; Luo, D.; Zhou, Q.; Chai, X.; Zhang, J.; Xie, W.; Liu, W.; Dong, Y.; Wang, Y. Transcriptome analyses reveal candidate pod shattering-associated genes involved in the pod ventral sutures of common vetch (Vicia sativa L.). Front. Plant Sci. 2017, 8, 649. [Google Scholar] [CrossRef]
- Kawai, S.; Hashimoto, W.; Murata, K. Transformation of Saccharomyces cerevisiae and other fungi: Methods and possible underlying mechanism. Bioeng. Bugs 2010, 1, 395–403. [Google Scholar] [CrossRef]

| ERF Groups | No of Genes | Length (aa) | Molecular Weight (Da) | pI | GRAVY | ||||||||
|---|---|---|---|---|---|---|---|---|---|---|---|---|---|
| Max. | Min. | Avg. | Max. | Min. | Avg. | Max. | Min. | Avg. | Max. | Min. | Avg. | ||
| ERF-I | 6 | 432 | 296 | 362 | 48,782 | 26,888 | 40,630 | 8.7 | 5.18 | 6.70 | −0.50 | −1.02 | −0.67 |
| ERF-II | 10 | 245 | 155 | 199 | 26,888 | 17,822 | 22,134 | 8.73 | 4.67 | 6.26 | −0.36 | −1.05 | −0.59 |
| ERF-III | 20 | 308 | 173 | 224 | 34,906 | 18,886 | 24,968 | 7.91 | 4.62 | 5.83 | −0.31 | −0.94 | −0.62 |
| ERF-IV | 9 | 506 | 195 | 295 | 56,148 | 20,927 | 32,730 | 9.21 | 4.86 | 6.82 | −0.44 | −0.99 | −0.75 |
| ERF-V | 8 | 309 | 176 | 225 | 39,747 | 34,573 | 25,299 | 9.32 | 5.7 | 7.22 | −0.61 | −0.81 | −0.70 |
| ERF-VI | 6 | 355 | 216 | 271 | 39,748 | 24,196 | 30,327 | 9.19 | 4.77 | 5.72 | −0.62 | −0.73 | −0.68 |
| ERF-VI-L | 2 | 385 | 265 | 338 | 41,535 | 32,026 | 36,780 | 6.68 | 5.15 | 6.005 | −0.66 | −0.79 | −0.72 |
| ERF-VII | 4 | 371 | 287 | 329 | 42,402 | 29,227 | 36,742 | 5.82 | 4.75 | 5.09 | −0.47 | −0.96 | −0.73 |
| ERF-VIII | 13 | 352 | 144 | 248 | 38,846 | 16,465 | 27,309 | 10.19 | 4.88 | 7.84 | −0.21 | −1.07 | −0.68 |
| ERF-IX | 17 | 417 | 141 | 242 | 46,532 | 14,834 | 27,132 | 9.33 | 4.73 | 7.05 | −0.41 | −0.87 | −0.66 |
| ERF-X | 5 | 417 | 171 | 304 | 45,288 | 19,032 | 33,463 | 8.69 | 6.08 | 6.93 | −0.71 | −1.08 | −0.81 |
| All | 100 | 506 | 141 | 276 | 56,148 | 14,834 | 30,683 | 10.19 | 4.62 | 6.49 | −0.21 | −1.08 | −0.69 |
| Sequance1 | Sequance2 | Ka | Ks | Ka_Ks | EffectiveLen | AverageS-Sites | AverageN-Sites |
|---|---|---|---|---|---|---|---|
| MaERF10 | MaERF89 | 0.642115 | 0.966072 | 0.664665 | 852 | 200.8333333 | 651.1666667 |
| MaERF10 | MaERF100 | 0.360433 | 0.676364 | 0.532898 | 1017 | 250.5833333 | 766.4166667 |
| MaERF13 | MaERF19 | 0.20672 | 1.432935 | 0.144263 | 519 | 120.5 | 398.5 |
| MaERF14 | MaERF23 | 0.233732 | 0.863167 | 0.270785 | 465 | 98.16666667 | 366.8333333 |
| MaERF15 | MaERF18 | 0.378074 | 1.842193 | 0.20523 | 720 | 154.8333333 | 565.1666667 |
| MaERF20 | MaERF64 | 0.338863 | 1.741791 | 0.194549 | 606 | 133.1666667 | 472.8333333 |
| MaERF21 | MaERF29 | 0.344693 | 1.521477 | 0.226552 | 561 | 125.25 | 435.75 |
| MaERF26 | MaERF88 | 0.422522 | 1.191733 | 0.354545 | 873 | 193.5 | 679.5 |
| MaERF26 | MaERF97 | 0.280705 | 0.812429 | 0.345514 | 990 | 225.9166667 | 764.0833333 |
| MaERF27 | MaERF99 | 0.235774 | 0.406662 | 0.579779 | 642 | 144.4166667 | 497.5833333 |
| MaERF34 | MaERF79 | 0.204008 | 0.839805 | 0.242923 | 780 | 167.4166667 | 612.5833333 |
| MaERF42 | MaERF80 | 0.246629 | 0.871625 | 0.282953 | 579 | 135.3333333 | 443.6666667 |
| MaERF43 | MaERF48 | 0.424768 | 2.126746 | 0.199727 | 558 | 136.3333333 | 421.6666667 |
| MaERF48 | MaERF83 | 0.372831 | 1.583792 | 0.235404 | 594 | 138.1666667 | 455.8333333 |
| MaERF50 | MaERF65 | 0.278726 | 0.672596 | 0.414404 | 846 | 184.8333333 | 661.1666667 |
| MaERF56 | MaERF66 | 0.504723 | 1.158554 | 0.435649 | 873 | 194.5 | 678.5 |
| MaERF57 | MaERF84 | 0.570869 | NaN | NaN | 567 | 130.5833333 | 436.4166667 |
| MaERF61 | MaERF74 | 0.313703 | 1.264034 | 0.248176 | 576 | 130.6666667 | 445.3333333 |
| MaERF90 | MaERF19 | 0.351229 | 2.145154 | 0.163731 | 537 | 125.1666667 | 411.8333333 |
Publisher’s Note: MDPI stays neutral with regard to jurisdictional claims in published maps and institutional affiliations. |
© 2022 by the authors. Licensee MDPI, Basel, Switzerland. This article is an open access article distributed under the terms and conditions of the Creative Commons Attribution (CC BY) license (https://creativecommons.org/licenses/by/4.0/).
Share and Cite
Wei, N.; Zhai, Q.; Li, H.; Zheng, S.; Zhang, J.; Liu, W. Genome-Wide Identification of ERF Transcription Factor Family and Functional Analysis of the Drought Stress-Responsive Genes in Melilotus albus. Int. J. Mol. Sci. 2022, 23, 12023. https://doi.org/10.3390/ijms231912023
Wei N, Zhai Q, Li H, Zheng S, Zhang J, Liu W. Genome-Wide Identification of ERF Transcription Factor Family and Functional Analysis of the Drought Stress-Responsive Genes in Melilotus albus. International Journal of Molecular Sciences. 2022; 23(19):12023. https://doi.org/10.3390/ijms231912023
Chicago/Turabian StyleWei, Na, Qingyan Zhai, Hang Li, Shuwen Zheng, Jiyu Zhang, and Wenxian Liu. 2022. "Genome-Wide Identification of ERF Transcription Factor Family and Functional Analysis of the Drought Stress-Responsive Genes in Melilotus albus" International Journal of Molecular Sciences 23, no. 19: 12023. https://doi.org/10.3390/ijms231912023
APA StyleWei, N., Zhai, Q., Li, H., Zheng, S., Zhang, J., & Liu, W. (2022). Genome-Wide Identification of ERF Transcription Factor Family and Functional Analysis of the Drought Stress-Responsive Genes in Melilotus albus. International Journal of Molecular Sciences, 23(19), 12023. https://doi.org/10.3390/ijms231912023

